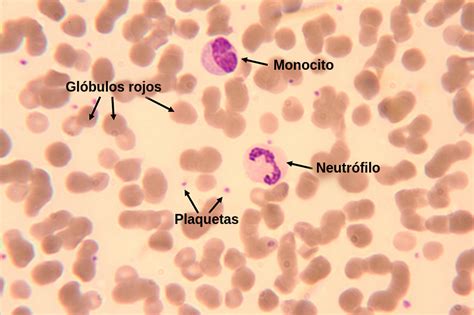
Microfotografía de un frotis de sangre periférica mostrando siderocitos (cuerpos de Pappenheimer)

La anemia sideroblástica es un grupo heterogéneo de trastornos sanguíneos que se caracterizan por la incapacidad del cuerpo para incorporar adecuadamente el hierro a la hemoglobina, la proteína esencial de los glóbulos rojos encargada del transporte de oxígeno. Esta afección puede manifestarse a través de diversos problemas de salud, como fatiga, debilidad y, en casos no tratados, complicaciones más graves.
Se define por la presencia de sideroblastos en anillo en la médula ósea, que son precursores anormales de glóbulos rojos que contienen un exceso de hierro acumulado en las mitocondrias. La síntesis del hemo se ve afectada debido a la incapacidad de incorporar hierro a la protoporfirina IX, lo que conduce a la formación de estos sideroblastos anulares.

Clasificación y Causas de la Anemia Sideroblástica
La anemia sideroblástica puede clasificarse en dos tipos principales: hereditaria (congénita) y adquirida (secundaria).
Anemia Sideroblástica Hereditaria (Congénita)
Las formas hereditarias suelen estar relacionadas con mutaciones genéticas que afectan a enzimas implicadas en la síntesis del hemo, provocando la acumulación de hierro en las mitocondrias de los precursores de glóbulos rojos. Estas mutaciones pueden ser:
- Ligadas al cromosoma X: La forma más común de anemia sideroblástica congénita (CSA) es debida a mutaciones en el gen ALAS2, que codifica la enzima 5'-aminolevulinato sintasa 2 (ALAS2), la principal reguladora de la síntesis del hemo. La incidencia de esta enfermedad es significativamente mayor en hombres. La edad de inicio clínico es variable, pudiendo presentarse desde el nacimiento hasta la edad adulta. Estos pacientes pueden responder al tratamiento con vitamina B6 (piridoxina) y ácido fólico.
- Autosómicas recesivas: Un tipo común es debido a mutaciones en el gen SLC25A38, que codifica una proteína transportadora mitocondrial esencial para la síntesis del ácido levulínico. Este tipo de anemia no responde al tratamiento con vitamina B6, y los pacientes a menudo requieren transfusiones de sangre regulares.
- Otras formas genéticas: Se han identificado mutaciones en otros genes como ABCB7 (asociada a ataxia espinocerebelosa), GLRX5 (codifica una enzima mitocondrial clave en la formación de agrupaciones de hierro/azufre), STEAP3/TSAP6 (implicado en la absorción de hierro por los glóbulos rojos), PUS1 y YARS2 (asociadas a miopatía mitocondrial y acidosis láctica - MLASA), SLC19A2 (causando anemia megaloblástica sensible a tiamina, diabetes mellitus tipo 1 y sordera neurosensorial), y TRNT1 (asociado a inmunodeficiencia de células B, fiebre periódica y retraso en el desarrollo - SIFD).
En general, las anemias sideroblásticas congénitas suelen presentarse durante la lactancia o la primera infancia, y a menudo cursan con anemia microcítica e hipocrómica.

Anemia Sideroblástica Adquirida
Las anemias sideroblásticas adquiridas son más frecuentes que las congénitas y suelen asociarse con:
- Síndromes Mielodisplásicos (SMD): Son trastornos clonales de las células madre hematopoyéticas. Las mutaciones somáticas, frecuentemente en el gen SF3B1, ocurren en la edad adulta. La sobrecarga de hierro es común en pacientes con SMD y afecta negativamente la supervivencia. La eritropoyesis ineficiente contribuye a la sobrecarga de hierro incluso antes de las transfusiones.
- Fármacos: Ciertos medicamentos como el cloranfenicol, isoniazida, linezolida, cicloserina y pirazinamida pueden inducir anemia sideroblástica.
- Tóxicos: La exposición a metales pesados como el plomo, el etanol (consumo abusivo de alcohol) y la ingesta excesiva de zinc (que puede interferir con la absorción de cobre) también pueden ser causas.
- Deficiencias nutricionales: Particularmente la deficiencia de vitamina B6 (piridoxina), que es esencial para la síntesis del hemo, o la carencia de cobre.
- Otras condiciones médicas: Como artritis reumatoide, infecciones genitourinarias, cáncer (leucemia, linfoma de Hodgkin).
La anemia sideroblástica adquirida generalmente se presenta durante la edad adulta y puede cursar con anemia macrocítica o normocítica, a menudo con dimorfismo eritrocitario (presencia de glóbulos rojos de diferentes tamaños) e indices RDW elevados.
Manifestaciones Clínicas y Diagnóstico
Síntomas Principales
Los síntomas de la anemia sideroblástica son, en gran medida, los propios de cualquier tipo de anemia y pueden incluir:
- Fatiga y debilidad
- Palidez de la piel y mucosas
- Dificultad para respirar (disnea)
- Mareos
- Extremidades frías
- Esplenomegalia (agrandamiento del bazo)
- Problemas cardíacos
- Función hepática anormal
- Intolerancia a la glucosa
- Hiperpigmentación cutánea
- Letargo
No obstante, algunos pacientes pueden ser asintomáticos y el trastorno se descubre tras un cribado hematológico de rutina.
Sospecha Diagnóstica
Se sospecha de anemia sideroblástica en pacientes con:
- Anemia microcítica (glóbulos rojos más pequeños de lo normal) o normocítica.
- Alta RDW (glóbulos rojos de un tamaño superior al normal).
- Incremento del hierro sérico, la ferritina sérica y la saturación de transferrina.
Métodos Diagnósticos
El diagnóstico se realiza a través de una combinación de pruebas:
- Evaluación clínica: Historia clínica detallada y exploración física.
- Hemograma completo: Para evaluar los niveles de glóbulos rojos, hemoglobina y otros componentes sanguíneos.
- Recuento de reticulocitos: Para medir la producción de glóbulos rojos inmaduros.
- Frotis de sangre periférica: Observación microscópica de las células sanguíneas para identificar anomalías, como la presencia de siderocitos (glóbulos rojos con gránulos de hierro, también conocidos como cuerpos de Pappenheimer) y dimorfismo eritrocitario.
- Estudios del hierro: Medición de hierro sérico, ferritina sérica y saturación de transferrina para evaluar el estado del hierro en el organismo.
- Examen de médula ósea: Es crucial para la confirmación diagnóstica. Permite visualizar la hiperplasia eritroide y la presencia patognomónica de sideroblastos en anillo, que son eritroblastos con mitocondrias perinucleares distendidas y cargadas de hierro. Se pueden utilizar tinciones especiales para resaltar estos gránulos de hierro.
- Estudios genéticos: Pruebas para detectar mutaciones genéticas específicas, tanto hereditarias como adquiridas, que puedan ser la causa de la anemia.
- Medición de niveles de plomo sérico: Si se sospecha de exposición a tóxicos.
Tratamiento y Pronóstico
El tratamiento de la anemia sideroblástica depende en gran medida de su causa subyacente, su gravedad y las características individuales del paciente, incluyendo la edad (pacientes pediátricos o geriátricos).
Enfoques Terapéuticos
- Eliminación de agentes causantes: En casos adquiridos, suspender el consumo de alcohol, interrumpir el uso de fármacos causales o eliminar la exposición a tóxicos es el primer paso.
- Suplementos vitamínicos y minerales: La administración de suplementos de vitamina B6 (piridoxina) es fundamental, especialmente en las formas hereditarias ligadas al X que responden a este cofactor. También pueden ser útiles el ácido fólico y la tiamina, o suplementos de cobre si existe deficiencia.
- Agentes estimulantes de la eritropoyesis (ESA): La eritropoyetina (EPO) recombinante puede ser eficaz, especialmente en las anemias sideroblásticas asociadas a síndromes mielodisplásicos de bajo riesgo. El luspatercept es un tratamiento de primera línea para pacientes con SMD de bajo riesgo dependientes de transfusiones.
- Tratamiento de la sobrecarga de hierro: La terapia de quelación (con fármacos como deferoxamina, deferiprona o deferasirox) o la flebotomía se utilizan para prevenir o tratar el daño orgánico causado por la acumulación excesiva de hierro (hemosiderosis).
- Transfusiones sanguíneas: En casos de anemia severa o cuando otros tratamientos no son suficientes, las transfusiones periódicas de hemocomponentes son necesarias para mantener niveles adecuados de hemoglobina.
- Agentes hipometilantes (HMA): Como la 5-azacitidina o la decitabina, se emplean en pacientes con SMD con anillos de sideroblastos (MDS-RS) cuando los ESA no son efectivos o en presencia de citopenias asociadas.
- Trasplante de células madre alogénicas: Considerado una estrategia curativa para pacientes jóvenes con formas congénitas severas que dependen de transfusiones, aunque conlleva riesgos significativos como la enfermedad del injerto contra huésped.
Sesión AGOSTO 2015 "Leucemia mieloide crónica. Terapia de quelación de hierro: eficacia en SMD" 9
Pronóstico
El pronóstico para las personas con anemia sideroblástica varía considerablemente y depende de factores como:
- La causa subyacente (genética vs. adquirida, y la mutación específica).
- La gravedad de la anemia y la presencia de comorbilidades.
- La respuesta al tratamiento.
- La adherencia al régimen terapéutico.
El diagnóstico temprano y la implementación de un plan de tratamiento adecuado pueden mejorar significativamente los resultados y la calidad de vida de los pacientes.
tags: #anemia #sideroblastica #alteracion #metabolismo #hierro #intramitocondrial